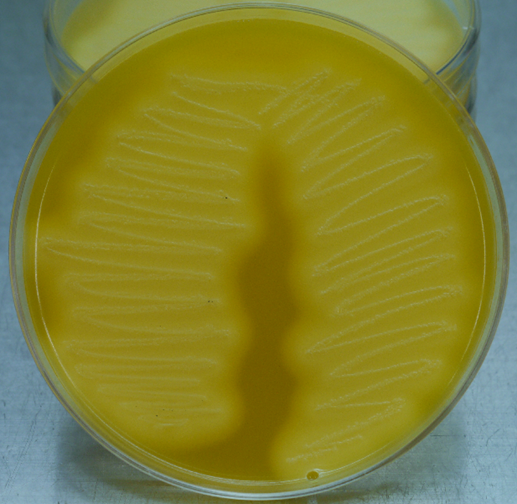
noname4.png

クラウドファンディング終了報告
プロジェクトを立ち上げたきっかけを振り返る

カラスの死因は、鳥インフルエンザが陰性だとわかると、それ以降は行政では一切検査が行われていません。
しかし、それだと大量死が発生した場合に不安によるパニックや、発見場所への風評が飛び交います。
鳥インフルエンザでニワトリなどが感染してしまうとは経済的なダメージが大きいですが、カラスなどの野鳥が感染した場合だと、経済的には困らないので死因を解明するにまで至りません。(鳥インフルエンザは感染源に濃厚な接触がない限り人には感染しませんが、野鳥間での感染は起こります)
カラスの死因は実に様々で、年齢や季節により変動も見られます。
死因解明は現在も進行していますが、より長いスパンで行うことが重要と思いました。
しかしながら、資金が厳しく自己資金も頼りない状態になっています。
カラスや野鳥への理解を深めて、死因を解明してより身近な存在になってもらえたらと考えています。
死因のデータがあると不必要にパニックになることもなく対応もしやすくなると考えています。
これがこのプロジェクトを立ち上げたきっかけでした。
本来なら行政の方で鳥インフルエンザ以外でも解明すべきだと思います。
死因解明の結果
2020年から2024年までの間に収集された183羽のカラスについて、死因の解明を目的として剖検を
行いました。
カラスの種別は、ハシブトガラスが140羽、ハシボソガラスが43羽でした。
雌雄は、♂106羽、♀74羽、性別不明は3羽でした。
(雌雄は死因には無関係です)
◆出血性腸炎が43羽(23.5%)
◆交通事故などのアクシデントは30羽(16.4%)
◆ポックスウイルス感染症は19羽(10.4%)
◆採食による死体損傷がみられたのは18羽(9.8%)
◆死後変化のため死因の特定が難しかったのは27羽(14.8%)
▶出血性腸炎はいわゆる「食中毒」です。カラスはゴミを食べるから食中毒というと驚く人がおいですが、完全に腐敗している物は食べませんし、食中毒は腐敗が原因ではありません。
▶意外と多いのが交通事故や建物などに激突死です。
トラックの荷台に激突するのを数回見ています。都会に暮らす以上は避けられないかもしれません。
▶ポックスウイルス感染症は2004年に札幌で初めて確認されて当時は大量死を招く寸前でしたが、現在は抗体ができたようで、発症数も少なくなりました。
◆採食による死体損傷ですが、死骸は貴重なタンパク源なので、同類のカラスや肉食哺乳類のキタキツネやトビなども食べています。
◆死後変化ですが、夏季は見た目以上に内臓の腐敗が早いですし、すぐにハエが集まろウジが発生してしまいます。
以下は、岩手大学農学部共同獣医学科獣医病理学研究室の佐々木淳助教からの報告です。



出血性腸炎の回腸、漿膜面(しょうまくめん_体腔内の臓器を包む最も外側の膜)と内腔が暗赤色を示している

出血性腸炎の組織像(弱拡大、HE染色_ヘマトキシリン・エオジン染色)
(ヘマトキシリンとエオジンという2つの染料を用いて組織や細胞を染色する技術)

病変部ではグラム陽性大桿菌(かんきん_棒状・円筒状の細)が多数みられる
(強拡大、グラム染色)
CW培地におけるレシチナーゼ陽性を示すコロニー
(CW培地_ウエルシュ菌の分離、推定同定用として考案された)
■死因として一番多くみられた出血性腸炎では、特に小腸後部の漿膜面(漿膜面_体腔内の臓器を包む最も外側の膜)、内腔が暗赤色を示し、組織学的には出血性腸炎の典型として認められました
■病変部では、グラム陽性大桿菌(かんきん_棒状・円筒状の細菌)が多数みられました
■小腸内容物から病原菌の分離を行ったところ、ヒトの食中毒の原因でもあるClostridium perfringen(クロストリジウム パーフリンジェンス) が分離されました
■これらの研究結果よりカラスの死因として一番多い出血性腸炎の原因はC.perfringensであることが明らかとなりました
※報告書の集計は2024/12までの症例データです※

まとめと考察
▶土壌には様々な菌などが常駐していて、カラス類が採餌によりClostridium perfringens(ウェルシュ菌)を取り込んでしまう確率は高いと思われます
▶ただし、冬期は積雪により、土壌がむき出しになることがほとんどないので、ゴミからと考えるのが自然だと思います
▶日常の行動から察するに、生ゴミから摂取しているが、事業系ではなく住宅街から出される、家庭ゴミからと考えられます
▶実際に5羽以上が同時に死亡していても、それ以降の継続がないのは、ゴミは当日中に回収されるからです
▶カラス類は貯食をする習性があるので、菌に侵されていた場合は、増殖してしまう可能性も考えられます
▶死骸を食べる習性もあるので、死亡した感染個体を食べることにより感染することも考えられます
▶死骸を食べる場合は、食べやすい内臓から食べることが多いので、それも感染要因の一つかもしれません
▶カラスの出血性腸炎を防ぐには生ゴミの管理を徹底して、食べさせないことが重要です
▶今後は行政や研究機関ではなくても、解剖などを簡単に依頼ができる仕組みが必要なのではと思います
収支について
●収入
クラウドファンディング達成額 ¥2,070,000 (第一目標額@¥700,000)
クラウドファンディング手数料 ¥387,090
入金額 ¥1,682,910
●支出
死因解明受託研究費 ¥600,000(過去自己負担分相殺分含)
送料 ¥298,820
鳥インフルエンザ検査簡易キット ¥100,000
検査試薬 ¥100,000
梱包材・保冷剤など ¥13,428
鳥学会費用 ¥238,210
保険代 ¥142,800
啓発グッズ(パンフレットなど) ¥153,830
活動維持経費(光熱費など) ¥42,890
雑費 ¥6,780
合計 ¥1,696,758
ご支援への感謝
この度は皆様のご協力で無事に事業を達成することができました。
死因解明はこれからも継続してまいります。近年札幌市内で発生している、高病原性鳥インフルエンザもあり気が抜けない毎日です。
今後は鳥インフルエンザの方も追及していきたいと思います。
その際はまたクラウドファンディングのお世話になると思いますが、よろしくお願いいたします。
感謝の上にまた感謝です。
今後もカラスのために調査研究に尽力して参りますので、皆さんの応援をお願いいたします。
事業実施に当たり、協力してくれた友人知人にも感謝いたします。
これからも暖かい目でご支援をお願いいたします。
2025/3/22
NPO法人札幌カラス研究会
代表理事 中村眞樹子






















